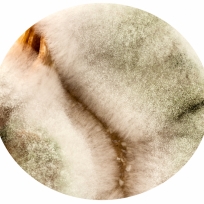

Metamorphose Projekt 8 – „(Puten)salami“ (19 Tage)
Das FUNGI – Mycelium– Projekt
Wer hat es nicht schon erlebt: da freut man sich auf einen leckeren Apfel oder ein Stück Käse und plötzlich … igittt schimmelig!!! Schnell in dem Mülleimer entsorgen und nicht mehr darüber nachdenken!
Mir ging es bislang genau so, bis ich während einem Tag der offenen Türe an der der Hochschule für bildende Künste (HbK) in Braunschweig ein Kunstprojekt gesehen habe, dass sich genau mit diesem Thema beschäftigte und mich seither nicht mehr losgelassen hat. Inspiriert durch dieses Kunstwerk habe ich Jahre später (2015) das Fotoprojekt „Fungi – Mycelium“ ins Leben gerufen.Die Schönheit von Schimmel-Pilzen (Fungi) erschließt sich vielleicht auch erst bei näherer Betrachtung und auf den zweiten Blick (oder gar nicht!).
Die Kommunikation meiner Projektidee an meine Umwelt polarisierte stark und es gab eigentlich nur zwei Reaktionen:
1. Ekel, Unverständnis … wie kannst Du das denn machen?
2. Faszination: das ist ja spannend, tolle Idee.
1. Ekel, Unverständnis … wie kannst Du das denn machen?
2. Faszination: das ist ja spannend, tolle Idee.
Mal ganz ehrlich, wer hat sich schon wirklich mal dazu überwunden sich die Verwandlung von Lebensmittel genauer anzusehen?

Thank you for your reading. Join the conversation by posting a comment.